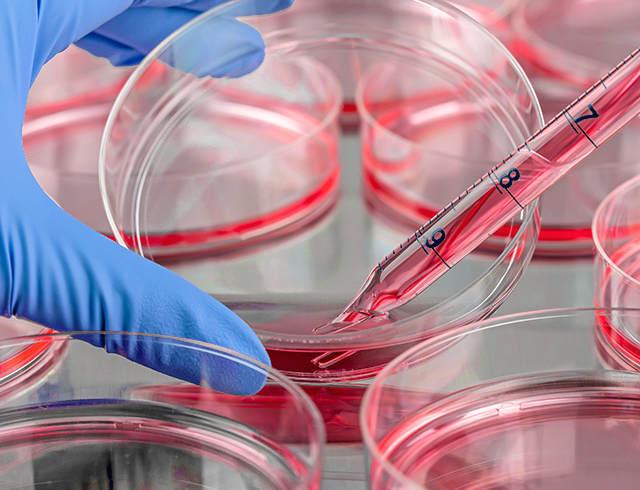

Creative BioMart, a leading provider of high-quality, comprehensive protein products and custom protein manufacturing services for over a decade, has recently launched stable cell line services for researchers and scientists in need of protein production and protein assay development.
Up to now, Creative BioMart provides thousands of high-quality protein products and custom protein manufacturing and assay services, including but not only recombinant proteins, native proteins, , protein analysis, protein expression, protein labeling. The newly launched stable cell line services have just expanded Creative BioMart’s advantages in the field of protein production.
For the stable cell line services, at this stage, Creative BioMart specializes the services in protein production grade stable cell lines, gene edited knock-out and knock-in custom cell lines, and assay grade stable cell lines. It claims to cover custom needs in the aspects of protein production and assay development.
“That’s true. With Creative BioMart’s system, stability could no longer be a problem in expressing the target protein. By saying STABLE, we mean even after 25 generations, our cell lines still remain comparably stable.” Said Miranda Sherwood, the Chief Scientist of Creative BioMart, “And we have successfully developed cell lines stable at level, both high and over. Moreover, we established cell lines stable and ready for protein assay development.”
With its expert scientist team with extensive experience and techniques, Creative BioMart is proud to announce that its stable cell line services as “time and money saving”.
“We could achieve in high productivity clone of stable cell lines approximately as short as in 12 weeks.” Added Dr. Miranda, “With this efficiency, we’re also able to lower the price for the same quantity. We’ll keep promoting our competency in this service.”
Details about Creative BioMart’s stable cell line services as well as quotations are already available on its website. Custom inquiries could also be sent to contact@creative-biomart.com. The company offers customer service 24 hours per day, Monday through Friday. To learn more about Creative BioMart’s stable cell line service, go and visit: .
About Creative BioMart:
With expertise as a leader in the field of protein products and efficient protein manufacturing techniques, Creative BioMart has started from a small supplier of proteins and enzymes for academic institutes and bio-tech companies and now developed into one of the most trustworthy bio-tech brands in the global market. Creative BioMart strives for its clients’ satisfaction in providing high-quality protein products and services for over 50 countries and districts. Creative BioMart is always on the way of innovation, keeping its fast space in expanding and providing more high quality protein products and services.